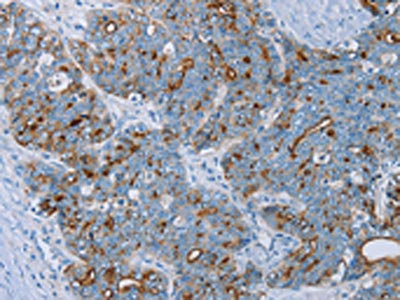

MUC1 Antibody
-
中文名稱:MUC1兔多克隆抗體
-
貨號(hào):CSB-PA692815
-
規(guī)格:¥1100
-
圖片:
-
The image on the left is immunohistochemistry of paraffin-embedded Human breast cancer tissue using CSB-PA692815(MUC1 Antibody) at dilution 1/45, on the right is treated with synthetic peptide. (Original magnification: ×200)
-
The image on the left is immunohistochemistry of paraffin-embedded Human cervical cancer tissue using CSB-PA692815(MUC1 Antibody) at dilution 1/45, on the right is treated with synthetic peptide. (Original magnification: ×200)
-
Gel: 6%SDS-PAGE,3T3 cell Lysate: 40 μg,,Primary antibody: CSB-PA692815(MUC1 Antibody) at dilution 1/200 dilution,Secondary antibody: Goat anti rabbit IgG at 1/8000 dilution,Exposure time: 5 minutes
-
-
其他:
產(chǎn)品詳情
-
Uniprot No.:
-
基因名:
-
別名:ADMCKD antibody; ADMCKD1 antibody; Breast carcinoma associated antigen DF3 antibody; Breast carcinoma-associated antigen DF3 antibody; CA 15-3 antibody; CA15 3 antibody; CA15 3 antigen antibody; CA15-3 antibody; CA15.3 antibody; Cancer antigen 15-3 antibody; Carcinoma associated mucin antibody; Carcinoma-associated mucin antibody; CD 227 antibody; CD227 antibody; DF3 antigen antibody; EMA antibody; Episialin antibody; Epithelial Membrane Antigen antibody; H23 antigen antibody; H23AG antibody; KL 6 antibody; KL-6 antibody; KL6 antibody; Krebs von den Lungen-6 antibody; MAM 6 antibody; MAM6 antibody; MCD antibody; MCKD antibody; MCKD1 antibody; Medullary cystic kidney disease 1 (autosomal dominant) antibody; Medullary cystic kidney disease, autosomal dominant antibody; MUC 1 antibody; MUC-1 antibody; MUC-1/SEC antibody; MUC-1/X antibody; MUC1 antibody; MUC1-alpha antibody; MUC1-beta antibody; MUC1-CT antibody; MUC1-NT antibody; MUC1/ZD antibody; MUC1_HUMAN antibody; Mucin 1 antibody; Mucin 1 cell surface associated antibody; Mucin 1 transmembrane antibody; Mucin 1, cell surface associated antibody; Mucin-1 subunit beta antibody; Peanut reactive urinary mucin antibody; Peanut-reactive urinary mucin antibody; PEM antibody; PEMT antibody; Polymorphic epithelial mucin antibody; PUM antibody; Tumor associated epithelial membrane antigen antibody; Tumor associated epithelial mucin antibody; Tumor associated mucin antibody; Tumor-associated epithelial membrane antigen antibody; Tumor-associated mucin antibody
-
宿主:Rabbit
-
反應(yīng)種屬:Human,Mouse
-
免疫原:Synthetic peptide of Human MUC1
-
免疫原種屬:Homo sapiens (Human)
-
標(biāo)記方式:Non-conjugated
-
抗體亞型:IgG
-
純化方式:Antigen affinity purification
-
濃度:It differs from different batches. Please contact us to confirm it.
-
保存緩沖液:Liquid?in?PBS?containing?50%?glycerol,?0.5%?BSA?and?0.02%?sodium?azide
-
產(chǎn)品提供形式:Liquid
-
應(yīng)用范圍:ELISA,WB,IHC
-
推薦稀釋比:
Application Recommended Dilution ELISA 1:1000-1:2000 WB 1:200-1:1000 IHC 1:30-1:150 -
Protocols:
-
儲(chǔ)存條件:Upon receipt, store at -20°C or -80°C. Avoid repeated freeze.
-
貨期:Basically, we can dispatch the products out in 1-3 working days after receiving your orders. Delivery time maybe differs from different purchasing way or location, please kindly consult your local distributors for specific delivery time.
-
用途:For Research Use Only. Not for use in diagnostic or therapeutic procedures.
相關(guān)產(chǎn)品
靶點(diǎn)詳情
-
功能:The alpha subunit has cell adhesive properties. Can act both as an adhesion and an anti-adhesion protein. May provide a protective layer on epithelial cells against bacterial and enzyme attack.; The beta subunit contains a C-terminal domain which is involved in cell signaling, through phosphorylations and protein-protein interactions. Modulates signaling in ERK, SRC and NF-kappa-B pathways. In activated T-cells, influences directly or indirectly the Ras/MAPK pathway. Promotes tumor progression. Regulates TP53-mediated transcription and determines cell fate in the genotoxic stress response. Binds, together with KLF4, the PE21 promoter element of TP53 and represses TP53 activity.
-
基因功能參考文獻(xiàn):
- Studied predictive use of mucin 1 (KL-6) serum level as a biomarker in development of bronchopulmonary dysplasia in preterm infants. PMID: 28425256
- we wanted to explore whether STAT3 can be related to lymph node micrometastasis of non-small cell lung cancer (NSCLC). To address this question, we evaluated the expression of MUC1 mRNA in the lymph node samples of NSCLC to determine micrometastasis. Then, we evaluated what role STAT3 overexpression plays in lymph node micrometastasis of NSCLC. PMID: 29575778
- these data showed that sustained abnormal MUC1 induction accompanies failing epithelial repair, chronic inflammation and kidney fibrosis. In conclusion, MUC1 exerts opposite effects during kidney response to IR: first protective and then harmful PMID: 28366875
- The expression profile of studied Mucins MUC16 and MUC1 and truncated O-glycans was not associated with the site of origin of ovarian cancer (OVCA) cell lines PMID: 30011875
- MUC1 contributes to immune escape in an aggressive form of triple-negative breast cancer.MUC1 drives PD-L1 expression in triple-negative breast cancer cells. PMID: 29263152
- Results show MUC1 expression highly expressed at mRNA and protein levels in esophageal squamous cell carcinoma (ESCC). MUC1 expression correlated with tumor invasion, lymph node metastasis, and TNM staging. PMID: 29798942
- Correlation was also observed in the % change of CA 15-3 and CA 27.29 results between consecutive specimens for individual patients. Using doubling or halving thresholds (i.e., 100% increase or 50% decrease), concordance in % change was observed between CA 15-3 and CA 27.29 in approximately 90% of cases. Individual patient results trended similarly across both markers over time PMID: 28929449
- Decreased expression of MUC1 is an independent marker for endometrial receptivity in recurrent implantation failure. PMID: 29929546
- The glycosylation level of CA153 was found to increase with increasing breast cancer stage in the sandwich assay. The assay system appeared to efficiently discriminate breast cancer stage I (sensitivity: 63%, specificity: 69%), IIA (sensitivity: 77%, specificity: 75%), IIB (sensitivity: 69%, specificity: 86%) and III (sensitivity: 80%, specificity: 65%) from benign breast disease. PMID: 29749490
- High MUC1 expression is associated with cervical cancer. PMID: 30062487
- KL-6 is an accurate biomarker for the diagnosis of interstitial lung disease in systemic sclerosis. PMID: 29455320
- MUC1 was a potential molecular target may help explain the role of lincRNA-ROR/miR-145 for invasion and metastasis in Triple-negative breast cancer cell lines. PMID: 29673594
- We have analysed the tumour-associated carbohydrate antigens sialyl-Lewis x (SLe(x)) and sialyl-Tn (STn) on MUC1 and MUC5AC in Pancreatic adenocarcinoma (PDAC)tissues. immunoprecipitation of MUC5AC from positive PDAC tissues and subsequent SLe(x) immunodetection confirmed the presence of SLe(x) on MUC5AC. Altogether, MUC5AC-SLe(x) glycoform is present in PDAC and can be regarded as potential biomarker. PMID: 29408556
- High MUC1 expression is associated with breast cancer metastasis. PMID: 29433529
- These results revealed that serum WFA-sialylated MUC1 was associated with histological features of hepatocellular carcinoma and recurrence after curative therapy. PMID: 28325920
- this study shows that basaloid squamous cell carcinoma and basal cell carcinoma of the head and neck can be readily distinguished by a limited panel consisting primarily of EMA, and supported by SOX2 and p16 PMID: 27438511
- In the in vitro tests, JFD-WS effectively inhibited HUVEC proliferation, migration, tube formation and VEGFR2 phosphorylation. Additionally, JFD-WS inhibited the formation of blood vessels in chick chorioallantoic membrane. While inhibiting the xenograft tumor growth in experimental mice, JFD-WS decreased the plasma MUC1 levels PMID: 29436685
- Quercetin suppressed breast cancer stem cell proliferation, self-renewal, and invasiveness. It also lowered the expression levels of proteins related to tumorigenesis and cancer progression, such as aldehyde dehydrogenase 1A1, C-X-C chemokine receptor type 4, mucin 1, and epithelial cell adhesion molecules. PMID: 29353288
- the proposed ECL immunosensor opened a new era for sensitive CA15-3 evaluation and offered a promising platform for clinical breast cancer diagnostics. PMID: 29278814
- MUC1-mediated nucleotide metabolism plays a key role in facilitating radiation resistance in pancreatic cancer and targeted effectively through glycolytic inhibition PMID: 28720669
- These findings indicate that decitabine intensifies MUC1-C inhibition induced redox imbalance and provides a novel combination of targeted and epigenetic agents for patients with Cutaneous T-cell lymphoma PMID: 28729399
- silencing MUC1 expression inhibited migration and invasion, and induced apoptosis of PANC-1 cells via downregulation of Slug and upregulation of Slug dependent PUMA and E-cadherin expression. PMID: 28869438
- this paper shows the role of IgG and Fcgamma receptor genes in endogenous antibody responses to mucin 1 in a large multiethnic cohort of Brazilian patients with breast cancer PMID: 29074302
- Frameshift mutation in MUC1 is associated with autosomal dominant tubulointerstitial kidney disease. PMID: 29156055
- MUC1 up-regulation is associated with castration-resistant prostate cancer and bone metastasis. PMID: 28930697
- As MUC1 and galectin-3 are both commonly overexpressed in most types of epithelial cancers, their interaction and impact on EGFR activation likely makes important contribution to EGFR-associated tumorigenesis and cancer progression. PMID: 28731466
- Results identified MUC1 as a novel target of 14-3-3zeta in lung adenocarcinoma. Its high expression is associated with poor survival in lung adenocarcinoma patients. PMID: 28901525
- In malignant epithelial ovarian tumors, the positive expression rates of Lewis(y) antigen and MUC1 were 88.33 and 86.67%, respectively, which were markedly higher than those in borderline (60.00 and 53.33%, P<0.05), benign (33.33 and 30%, P<0.01) and normal (0 and 25%, P<0.01) ovarian samples. PMID: 28586014
- In uninflamed CD ileum and IBD colon, most barrier gene levels restored to normal, except for MUC1 and MUC4 that remained persistently increased compared with controls. Genetic and transcriptomic dysregulations of key epithelial barrier genes and components in IBD. In particular MUC1 and MUC4, play an essential role in the pathogenesis of IBD and could represent interesting targets for treatment. PMID: 28885228
- this study implicates the MUC1 as a critical and dynamic component of the innate host response that limits the severity of influenza and provides the foundation for exploration of MUC1 in resolving inflammatory PMID: 28327617
- the observed G1 phase arrest completely agrees with the metabolomics results; MUC1-overexpressing cells under glucose limitation have an altered glutamine metabolism that results in a disruption in de novo pyrimidine synthesis that negatively impacts DNA replication. Moreover, our results provide a clear explanation for the observed glucose dependency of MUC1-overexpressing cells. PMID: 28809118
- Data suggest that ositive Mucin-1 (MUC1) expression in cell block cytology specimens may be associated with progressive dilation of the main and ectatic branches of pancreatic ducts. PMID: 28902782
- In conclusion, this meta-analysis suggested that rs4245739 polymorphism in the MUC1 gene may play a pivotal role in the pathogenesis of GC, especially for white populations PMID: 28561882
- In this paper, a dual-target electrochemical aptasensor has been developed for simultaneous detection of carcinoembryonic antigen and mucin-1 based on metal ion electrochemical labels and Ru(NH3)6(3+) electronic wires PMID: 28732346
- MUC1-C is upregulated in triple-negative breast cancer cells resistant to ABT-737 or ABT-263. PMID: 27217294
- MUC1 gene interference was done to A549 cells to show its role in sensitivity of lung cancer cells to TNFalpha and DEX. Results of our experiments indicate that MUC1 may regulate the influence of inflammatory mediators in effects of glucocorticoids (GCs), as a regulatory target to improve therapeutics. PMID: 28470556
- Mucin 1 is present in intervertebral disc tissue, and its expression is altered in disc degeneration. PMID: 28482827
- findings show that transmembrane mucins are receptors for the aggregative adherence fimbriae (AAF) adhesins of enteroaggregative Escherichia coli on the intestinal epithelium; demonstrate that the AAFs elicit intestinal inflammation through MUC1-mediated host cell signaling PMID: 28588132
- Report MUC1 gene amplification in association with prostate cancer metastasis and the development of castration resistant prostate cancer. PMID: 27825118
- In stage IV breast cancer, circulating antiMUC1 antibody was found to bind serum MUC1 antigen, although their compatibility was low. No significant difference was found in the affinity of the antiMUC1 antibody between stage IV breast cancer and earlystage breast cancer. PMID: 28447743
- findings suggest that these pulmonary markers could be useful to assess CAP severity and, especially YKL-40 and CCL18 by helping predict CAP caused by atypical pathogens PMID: 29324810
- In this Molecular Pathways article, we briefly discuss the potential role of mucin synthesis in cancers, ways to improve drug delivery and disrupt mucin mesh to overcome chemoresistance by targeting mucin synthesis, and the unique opportunity to target the GCNT3 pathway for the prevention and treatment of cancers. PMID: 28039261
- Only EMA was significantly associated with the expressions in circulating tumor cells (CTCs) and tissue. CTC detection was associated with higher T stage and portal vein invasion in hepatocellular carcinomas patients PMID: 27034142
- MUC1-C activates the NF-kappaB p65 pathway, promotes occupancy of the MUC1-C/NF-kappaB complex on the DNMT1 promoter and drives DNMT1 transcription PMID: 27259275
- MUC1 and MUC4 expression are increased by hypoxia and DNA hypomethylation; this status is statistically associated with development of distant metastasis, tumor stage and overall survival for pancreatic ductal adenocarcinoma (stage IIA and IIB) patients PMID: 27283771
- MUC1 enhancement of ERK activation influences FRA-1 activity to modulate tumor migration, invasion and metastasis in a subset of pancreatic cancer cases PMID: 27220889
- MUC1 plays an important role in Tumor-associated macrophage-induced lung cancer stem cell progression; pterostilbene may have therapeutic potential for modulating the unfavorable effects of TAMs in lung cancer progression PMID: 27276704
- The presence of the MUC1 molecules containing TR subdomain (MUC1-TR) on the surface of low-invasive cancer cells leads to the increase in their transendothelial migration potency, while the addition of the IR subdomain to the MUC1-TR molecule (MUC1-IR-TR) restores their natural low invasiveness. PMID: 28407289
- MUC1-driven EGFR expression and signaling regulates proliferation of endometrial cancer cells. PMID: 27092881
- MUC1-C binds directly with CD44v and in turn promotes stability of xCT in the cell membrane PMID: 26930718
顯示更多
收起更多
-
相關(guān)疾病:Medullary cystic kidney disease 1 (MCKD1)
-
亞細(xì)胞定位:Apical cell membrane; Single-pass type I membrane protein. Note=Exclusively located in the apical domain of the plasma membrane of highly polarized epithelial cells. After endocytosis, internalized and recycled to the cell membrane. Located to microvilli and to the tips of long filopodial protusions.; [Isoform 5]: Secreted.; [Isoform Y]: Secreted.; [Isoform 9]: Secreted.; [Mucin-1 subunit beta]: Cell membrane. Cytoplasm. Nucleus. Note=On EGF and PDGFRB stimulation, transported to the nucleus through interaction with CTNNB1, a process which is stimulated by phosphorylation. On HRG stimulation, colocalizes with JUP/gamma-catenin at the nucleus.
-
組織特異性:Expressed on the apical surface of epithelial cells, especially of airway passages, breast and uterus. Also expressed in activated and unactivated T-cells. Overexpressed in epithelial tumors, such as breast or ovarian cancer and also in non-epithelial tum
-
數(shù)據(jù)庫(kù)鏈接:
Most popular with customers
-
Phospho-YAP1 (S127) Recombinant Monoclonal Antibody
Applications: ELISA, WB, IHC
Species Reactivity: Human
-
-
-
-
-
-
-
VDAC1 Recombinant Monoclonal Antibody
Applications: ELISA, WB, IHC
Species Reactivity: Human, Mouse, Rat